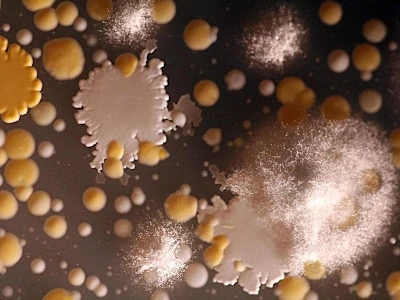
Schwingen

Some cheeses are mild and soft like mozzarella, others are salty-hard like Parmesan. And some smell pungent like Époisses, a funky orange cheese from the Burgundy region in France. There are cheeses with fuzzy rinds such as Camembert, and ones marbled with blue veins such as Cabrales, which ripens for months in mountain caves in northern Spain.
Yet almost all of the world's thousand-odd kinds of cheese start the same, as a white, rubbery lump of curd.
How do we get from that uniform blandness to this cornucopia? The answer revolves around microbes. Cheese teems with bacteria, yeasts and molds. More than 100 different microbial species can easily be found in a single cheese type. In other words: Cheese isn't just a snack, it's an ecosystem. Every slice contains billions of microbes — and they are what makes cheeses distinctive and delicious.
People have made cheese since the late Stone Age, but only recently have scientists begun to study its microbial nature and learn about the deadly skirmishes, peaceful alliances and beneficial collaborations that happen between the organisms that call cheese home.
To find out what bacteria and fungi are present in cheese and where they come from, scientists sample cheeses from all over the world and extract the DNA they contain. By matching the DNA to genes in existing databases, they can identify which organisms are present in the cheese.
Early on, that search yielded surprises. For example, cheesemakers often add starter cultures of beneficial bacteria to freshly formed curds to help a cheese on its way. Yet when the ripened cheeses were examined, it was found that the microbial mixes — microbiomes — of the cheeses showed only a passing resemblance to those cultures. Often, more than half of the bacteria present were microbial “strangers” that had not been in the starter culture. Where did they come from?Many of these microbes turned out to be old acquaintances, but ones we usually know from places other than cheese. Take Brachybacterium, a microbe present in Gruyère, which is more commonly found in soil, seawater and chicken litter (and perhaps even an Etruscan tomb). Or bacteria of the genus Halomonas, which are usually associated with salt ponds and marine environments. Then there's Brevibacterium linens, a bacterium that has been identified as a central contributor to the stinkiness of Limburger. When not on cheese, it can often be found in damp areas of our skin such as between our toes. B. linens also adds characteristic notes to the odor of sweat.
Initially, researchers were dumbfounded by how some of these microbes ended up on and in cheese. Yet, as they sampled the environment of cheesemaking facilities, a picture began to emerge. The milk of cows (or goats or sheep) contains some microbes from the get-go. But many more are picked up during the milking and cheesemaking process. Soil bacteria lurking in a stable's straw bedding might attach themselves to the teats of a cow and end up in the milking pail, for example. Skin bacteria fall into the milk from the hand of the milker or get transferred by the knife that cuts the curd. Other microbes enter the milk from the storage tank or simply drift down off the walls of the dairy facility.
Staphylococcus xylosus and the white ones are S. succinus. The small round colonies are several species of Brevibacterium, and the fuzzy white colony is a Penicillium mold. Courtesy of the Wolfe Lab, Tufts University
Some microorganisms are probably brought in from surprisingly far away. Researchers now suspect that marine microbes such as Halomonas get to the cheese via the sea salt in the brine that cheesemakers use to wash down their cheeses.
A simple, fresh white cheese like petit-suisse from Normandy might mostly contain microbes of a single species or two. But in long-ripened cheeses such as Roquefort, researchers have detected hundreds of different kinds of bacteria and fungi. In some cheeses, more than 400 different kinds have been found. Furthermore, by repeatedly testing, scientists have observed that there can be a sequence of microbial settlements whose rise and fall can rival that of empires.
Consider Bethlehem, a raw milk cheese made by Benedictine nuns in the Abbey of Regina Laudis in Connecticut. Between the day it gets made (or “born,” as cheesemakers say) to when it's fully ripe about a month later, Bethlehem changes from a rubbery, smooth disk to one with a dusty white rind sprouting tiny fungal hair, and eventually to a darkly mottled surface. If you were to look with a strong microscope, you could watch as the initially smooth rind becomes a rugged, pocketed terrain so densely packed with organisms that they form biofilms similar to the microbial mats around bathroom drains. A single gram of rind from a fully ripened cheese might contain a good 10 billion bacteria, yeasts and other fungi.

But the process usually starts simply. Typically, the first microbial settlers in milk are lactic acid bacteria (LABs). These LABs feed on lactose, the sugar in the milk, and as their name implies, they produce acid from it. The increasing acidity causes the milk to sour, making it inhospitable for many other microbes.
However, a select few microorganisms can abide this acid environment, among them certain yeasts such as Saccharomyces cerevisiae (baker's yeast). These microbes move into the souring milk and feed on the lactic acid that LABs produce. In doing so, they neutralize the acidity, eventually allowing other bacteria such as B. linens to join the cheesemaking party.
As the various species settle in, territorial struggles can ensue. A study in 2020 that looked at 55 artisanal Irish cheeses found that almost one in three cheese microbes possessed genes needed to produce “weapons” — chemical compounds that kill off rivals. At this point it isn't clear if and how many of these genes are switched on. (Should these compounds be potent enough, the hope is that one day they might become sources for new antibiotics.)
But cheese microbes also cooperate. For example, the Saccharomyces cerevisiae yeasts that eat the lactic acid produced by the LABs return the favor by manufacturing vitamins and other compounds that the LABs need. In a different sort of cooperation, threadlike fungal filaments can act as “roads” for surface bacteria to travel deep into the interior of a cheese.By now you might have started to suspect: Cheese is fundamentally about decomposition. Like microbes on a rotten log in the woods, the bacteria and fungi in cheese break down their environment — in this case, the milk fats and proteins. This makes cheeses creamy and gives them flavor.

According to Mother Noella Marcellino, longtime Benedictine cheesemaker at the Abbey of Regina Laudis “Cheese shows us what goodness can come from decay. Humans don't want to look at death, because it means separation and the end of a cycle. But it's also the start of something new. Decomposition creates this wonderful aroma and taste of cheese while evoking a promise of life beyond death.”
Exactly how the microbes build flavor is still being investigated. But a few things already stand out. Lactic acid bacteria, for example, produce volatile compounds called acetoin and diacetyl that can also be found in butter and accordingly give cheeses a rich, buttery taste. A yeast called Geotrichum candidum brings forth a blend of alcohols, fatty acids and other compounds that impart the moldy yet fruity aroma characteristic of cheeses such as Brie or Camembert. Then there's butyric acid, which smells rancid on its own but enriches the aroma of Parmesan, and volatile sulfur compounds whose cooked-cabbage smell blends into the flavor profile of many mold-ripened cheeses like Camembert. All a cheesemaker does is set the right conditions for the “rot” of the milk. Different bacteria and fungi thrive at different temperatures and different humidity levels, so every step along the way introduces variety and nuance. If a cheesemaker heats the milk to over 120 degrees Fahrenheit, for example, only heat-loving bacteria like Streptococcus thermophilus will survive — perfect for making cheeses like mozzarella.
Cutting the curd into large chunks means that it will retain a fair amount of moisture, which will lead to a softer cheese like Camembert. On the other hand, small cubes of curd drain better, resulting in a drier curd — something you want for, say, a cheddar.Storing the young cheese at warmer or cooler temperatures will again encourage some microbes and inhibit others, as does the amount of salt that is added. So when cheesemakers wash their ripening rounds with brine, it not only imparts seasoning but also promotes colonies of salt-loving bacteria like B. linens that promptly create a specific kind of orangey, sticky rind.
Cheesemakers say even the tiniest changes in how a cheese is handled can alter its microbiome, and thus the cheese itself. Switch on the air exchanger in the ripening room by mistake so that more oxygen flows around the cheese and suddenly molds will sprout that haven't been there before. But surprisingly, as long as the conditions remain the same, the same communities of microbes will show up again and again, researchers have found. Put differently: The same microbes can be found almost everywhere. If a cheesemaker sticks to the recipe for a Camembert — always heats the milk to the relevant temperature, cuts the curd to the right size, ripens the cheese at the appropriate temperature and moisture level — the same species will flourish and an almost identical kind of Camembert will develop, whether it's on a farm in Normandy, in a cheesemaker's cave in Vermont or in a steel-clad dairy factory in Wisconsin.
Some cheesemakers had speculated that cheese was like wine, which famously has a terroir — that is, a specific taste that is tied to its geography and is rooted in the vineyard's microclimate and soil. But apart from subtle nuances, if everything goes well in production, the same cheese type always tastes the same no matter where or when it's made.
By now, some microbes have been making cheese for people for so long that they have become “domesticated.” In Switzerland, cheesemakers traditionally hold back part of the whey from a batch of cheese to use again when making the next one. It's called backslopping, and some starter cultures have been continuously backslopped for months, years, and even centuries. During that time, the backslopped microbes have lost genes that are no longer useful for them in their specialized dairy environment, such as some genes needed to metabolize carbohydrates other than lactose, the only sugar found in milk.
But not only has cheesemaking become tamer over time, it is also cleaner than it used to be — and this has had consequences for its ecosystem. These days, many cows are milked by machines and the milk is siphoned directly into the closed systems of hermetically sealed, ultra-filtered storage tanks, protected from the steady rain of microbes from hay, humans and walls that settled on the milk in more traditional times.
Often the milk is pasteurized, too — that is, briefly heated to high temperatures to kill the bacteria that come naturally with it. Then, they're replaced with standardized starter cultures. All of this has made cheesemaking more controlled. But alas, it also means that there's less diversity of microbes in our cheeses. Many of our cheddars, provolones and Camemberts, once wildly proliferating microbial meadows, have become more like manicured lawns. And because every microbe contributes its own signature mix of chemical compounds to a cheese, less diversity also means less flavor — a big loss.
See also
